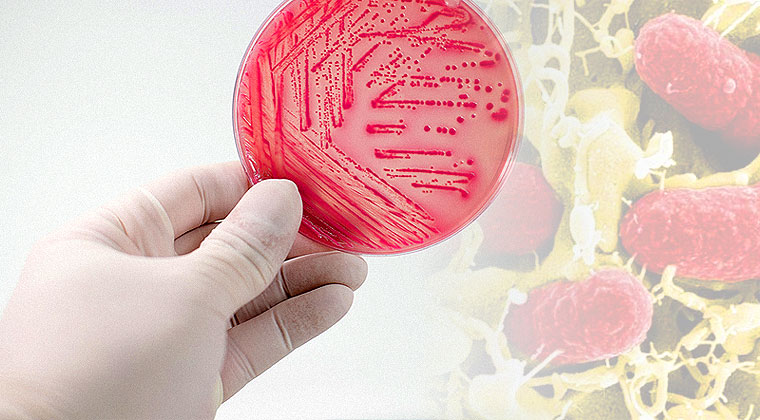

El SUH es una enfermedad poco frecuente pero potencialmente grave, especialmente en niños pequeños. Conocer cómo se transmite y cómo prevenirlo es clave para reducir riesgos.
El Síndrome Urémico Hemolítico (SUH) es una enfermedad que, aunque no es frecuente, puede tener consecuencias serias, sobre todo en la infancia. En nuestro país, sigue siendo un tema relevante en salud, por lo que la prevención cumple un rol fundamental.
En la mayoría de los casos, el SUH está asociado a una bacteria llamada Escherichia coli productora de toxina Shiga, que puede encontrarse en alimentos contaminados.
💬 El SUH no es una enfermedad común, pero sí es prevenible en gran medida si incorporamos medidas adecuadas en la manipulación y el consumo de alimentos.
🍔 ¿Dónde está el principal riesgo?
Uno de los principales focos de contagio es la carne, especialmente la carne picada. Esto se debe a que la bacteria puede encontrarse en la superficie de la carne y, al procesarse, distribuirse en todo el producto.
Por este motivo, alimentos como hamburguesas, empanadas o pastel de papas deben cocinarse completamente, asegurando también la cocción en su interior.
💬 La carne picada tiene mayor riesgo porque, si no está bien cocida, la bacteria puede permanecer en su interior.
Además, la bacteria puede estar presente en:
- Agua o alimentos contaminados
- Carne cruda o poco cocida
- Leche y productos lácteos no pasteurizados
👶🏻 ¿Por qué afecta más a niños?
Los niños pequeños son más vulnerables porque su sistema inmune, especialmente a nivel intestinal, aún no está completamente desarrollado. Esto los hace más susceptibles a infecciones graves.
Por eso, es fundamental evitar en la infancia el consumo de alimentos de riesgo, especialmente carne picada mal cocida y productos lácteos no pasteurizados.
⚠️ ¿Cómo se transmite?
El contagio puede producirse por:
- Ingesta de alimentos contaminados
- Contacto con superficies contaminadas
- Manipulación inadecuada de alimentos
- Contacto con heces de animales infectados
La higiene y la correcta manipulación de alimentos son claves para prevenir la infección.

🚨 Síntomas de alerta
El cuadro puede comenzar con síntomas digestivos y evolucionar rápidamente. Es importante prestar atención a:
- Diarrea (en algunos casos con sangre)
- Dolor abdominal
- Fatiga o debilidad
- Disminución en la cantidad de orina
Ante estos signos, es fundamental consultar de manera inmediata.
🧼 Medidas de prevención
El SUH es, en gran parte, prevenible. Algunas recomendaciones fundamentales son:
- Evitar la contaminación cruzada en la cocina
- Cocinar completamente la carne, especialmente la carne picada
- Evitar el consumo de carnes crudas o poco cocidas
- Consumir únicamente lácteos pasteurizados
- Lavar frutas y verduras antes de consumirlas
- Mantener una correcta higiene de manos
💬 Cierre
El Síndrome Urémico Hemolítico es una enfermedad grave, pero prevenible en muchos casos. Incorporar hábitos seguros en la cocina y reforzar las medidas de higiene puede marcar una diferencia significativa, especialmente en la salud de los niños.
Cuidar la alimentación y la manipulación de los alimentos es una forma concreta de prevención.
Ante cualquier duda o síntoma, la consulta médica oportuna es fundamental.



















